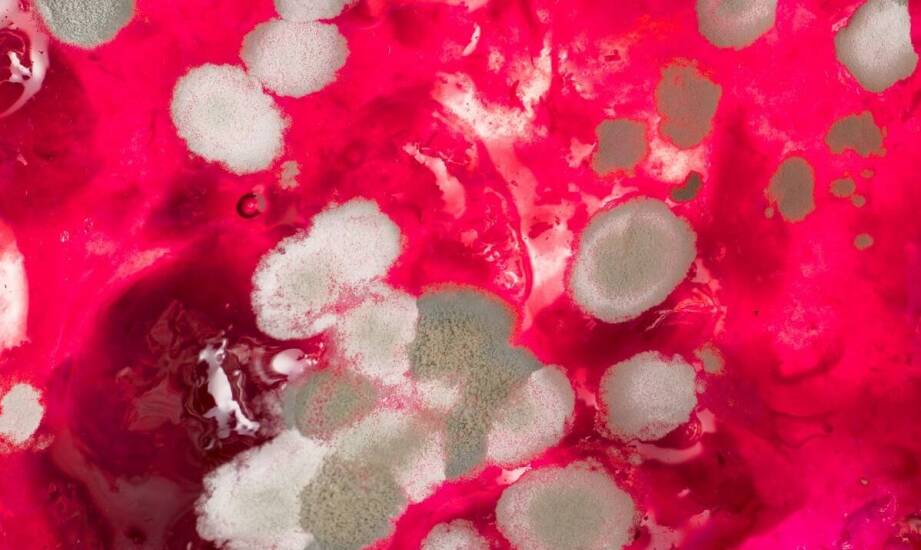
Wpływ histopatologicznych analiz na rozwój kardiologicznych terapii

Artykuł sponsorowany
Wpływ histopatologicznych analiz na rozwój kardiologicznych terapii
Analizy histopatologiczne są niezbędne w nowoczesnej kardiologii, umożliwiając zrozumienie patologii chorób sercowo-naczyniowych. Dzięki nim identyfikowane są zmiany w tkankach, co wspiera rozwój nowych terapii. Wprowadzenie to podkreśla znaczenie badań w kontekście współczesnej medycyny sercowo-naczyniowej oraz ich rolę w ocenie przebiegu leczenia i bezpieczeństwa pacjentów w American Heart of Poland S. A. w Katowicach.
Techniki histopatologiczne w badaniach kardiologicznych
W badaniach kardiologicznych stosuje się różnorodne techniki histopatologiczne, które pozwalają na dokładną ocenę stanu tkanek serca i naczyń. Proces rozpoczyna się od przygotowania próbek, które następnie poddawane są barwieniu, co umożliwia ich analizę mikroskopową. Dzięki temu specjaliści mogą ocenić zmiany morfologiczne oraz stopień uszkodzenia tkanek. Zrozumienie tych metod jest kluczowe dla interpretacji wyników oraz ich zastosowania w praktyce klinicznej. Warto zaznaczyć, że współpraca z ośrodkami badawczymi, takimi jak American Heart of Poland S. A., może wspierać realizację analiz oraz rozwój terapii kardiologicznych w Katowicach i okolicach.
Wpływ wyników histopatologicznych na terapie kardiologiczne
American Heart of Poland S. A. prowadzi badania kliniczne, w których wyniki analiz histopatologicznych są uwzględniane w decyzjach terapeutycznych. Przykładem może być badanie dotyczące stentów naczyniowych, gdzie analiza tkanek pomogła ocenić działanie i profil bezpieczeństwa stosowanych rozwiązań. Dzięki temu lekarze mogli podejmować decyzje dotyczące leczenia pacjentów. Analizy te przyczyniają się również do rozwoju metod leczenia chorób serca, takich jak techniki operacyjne czy terapie komórkowe. Wspierają one rozwój kardiochirurgii, chirurgii naczyniowej oraz rehabilitacji. American Heart of Poland w Katowicach angażuje się w międzynarodowe badania kliniczne, co umożliwia wymianę wiedzy i doświadczeń oraz wspiera wprowadzanie nowych terapii do praktyki klinicznej.
Przyszłość histopatologii w kardiologii
W przyszłości tej dziedziny można oczekiwać nowych technologii oraz podejść, które mogą zrewolucjonizować diagnostykę i leczenie chorób sercowo-naczyniowych. Innowacje te będą miały istotne znaczenie dla poprawy jakości życia pacjentów, a ciągły rozwój podkreśli wagę badań i postępu. Warto zwrócić uwagę na potencjał współpracy międzynarodowej oraz wymiany doświadczeń między ośrodkami badawczymi i klinicznymi. Dzięki temu możliwe będzie sprawniejsze wdrażanie nowoczesnych rozwiązań terapeutycznych oraz lepsze dopasowanie leczenia schorzeń układu krążenia, co potwierdza rosnące zainteresowanie nimi.



